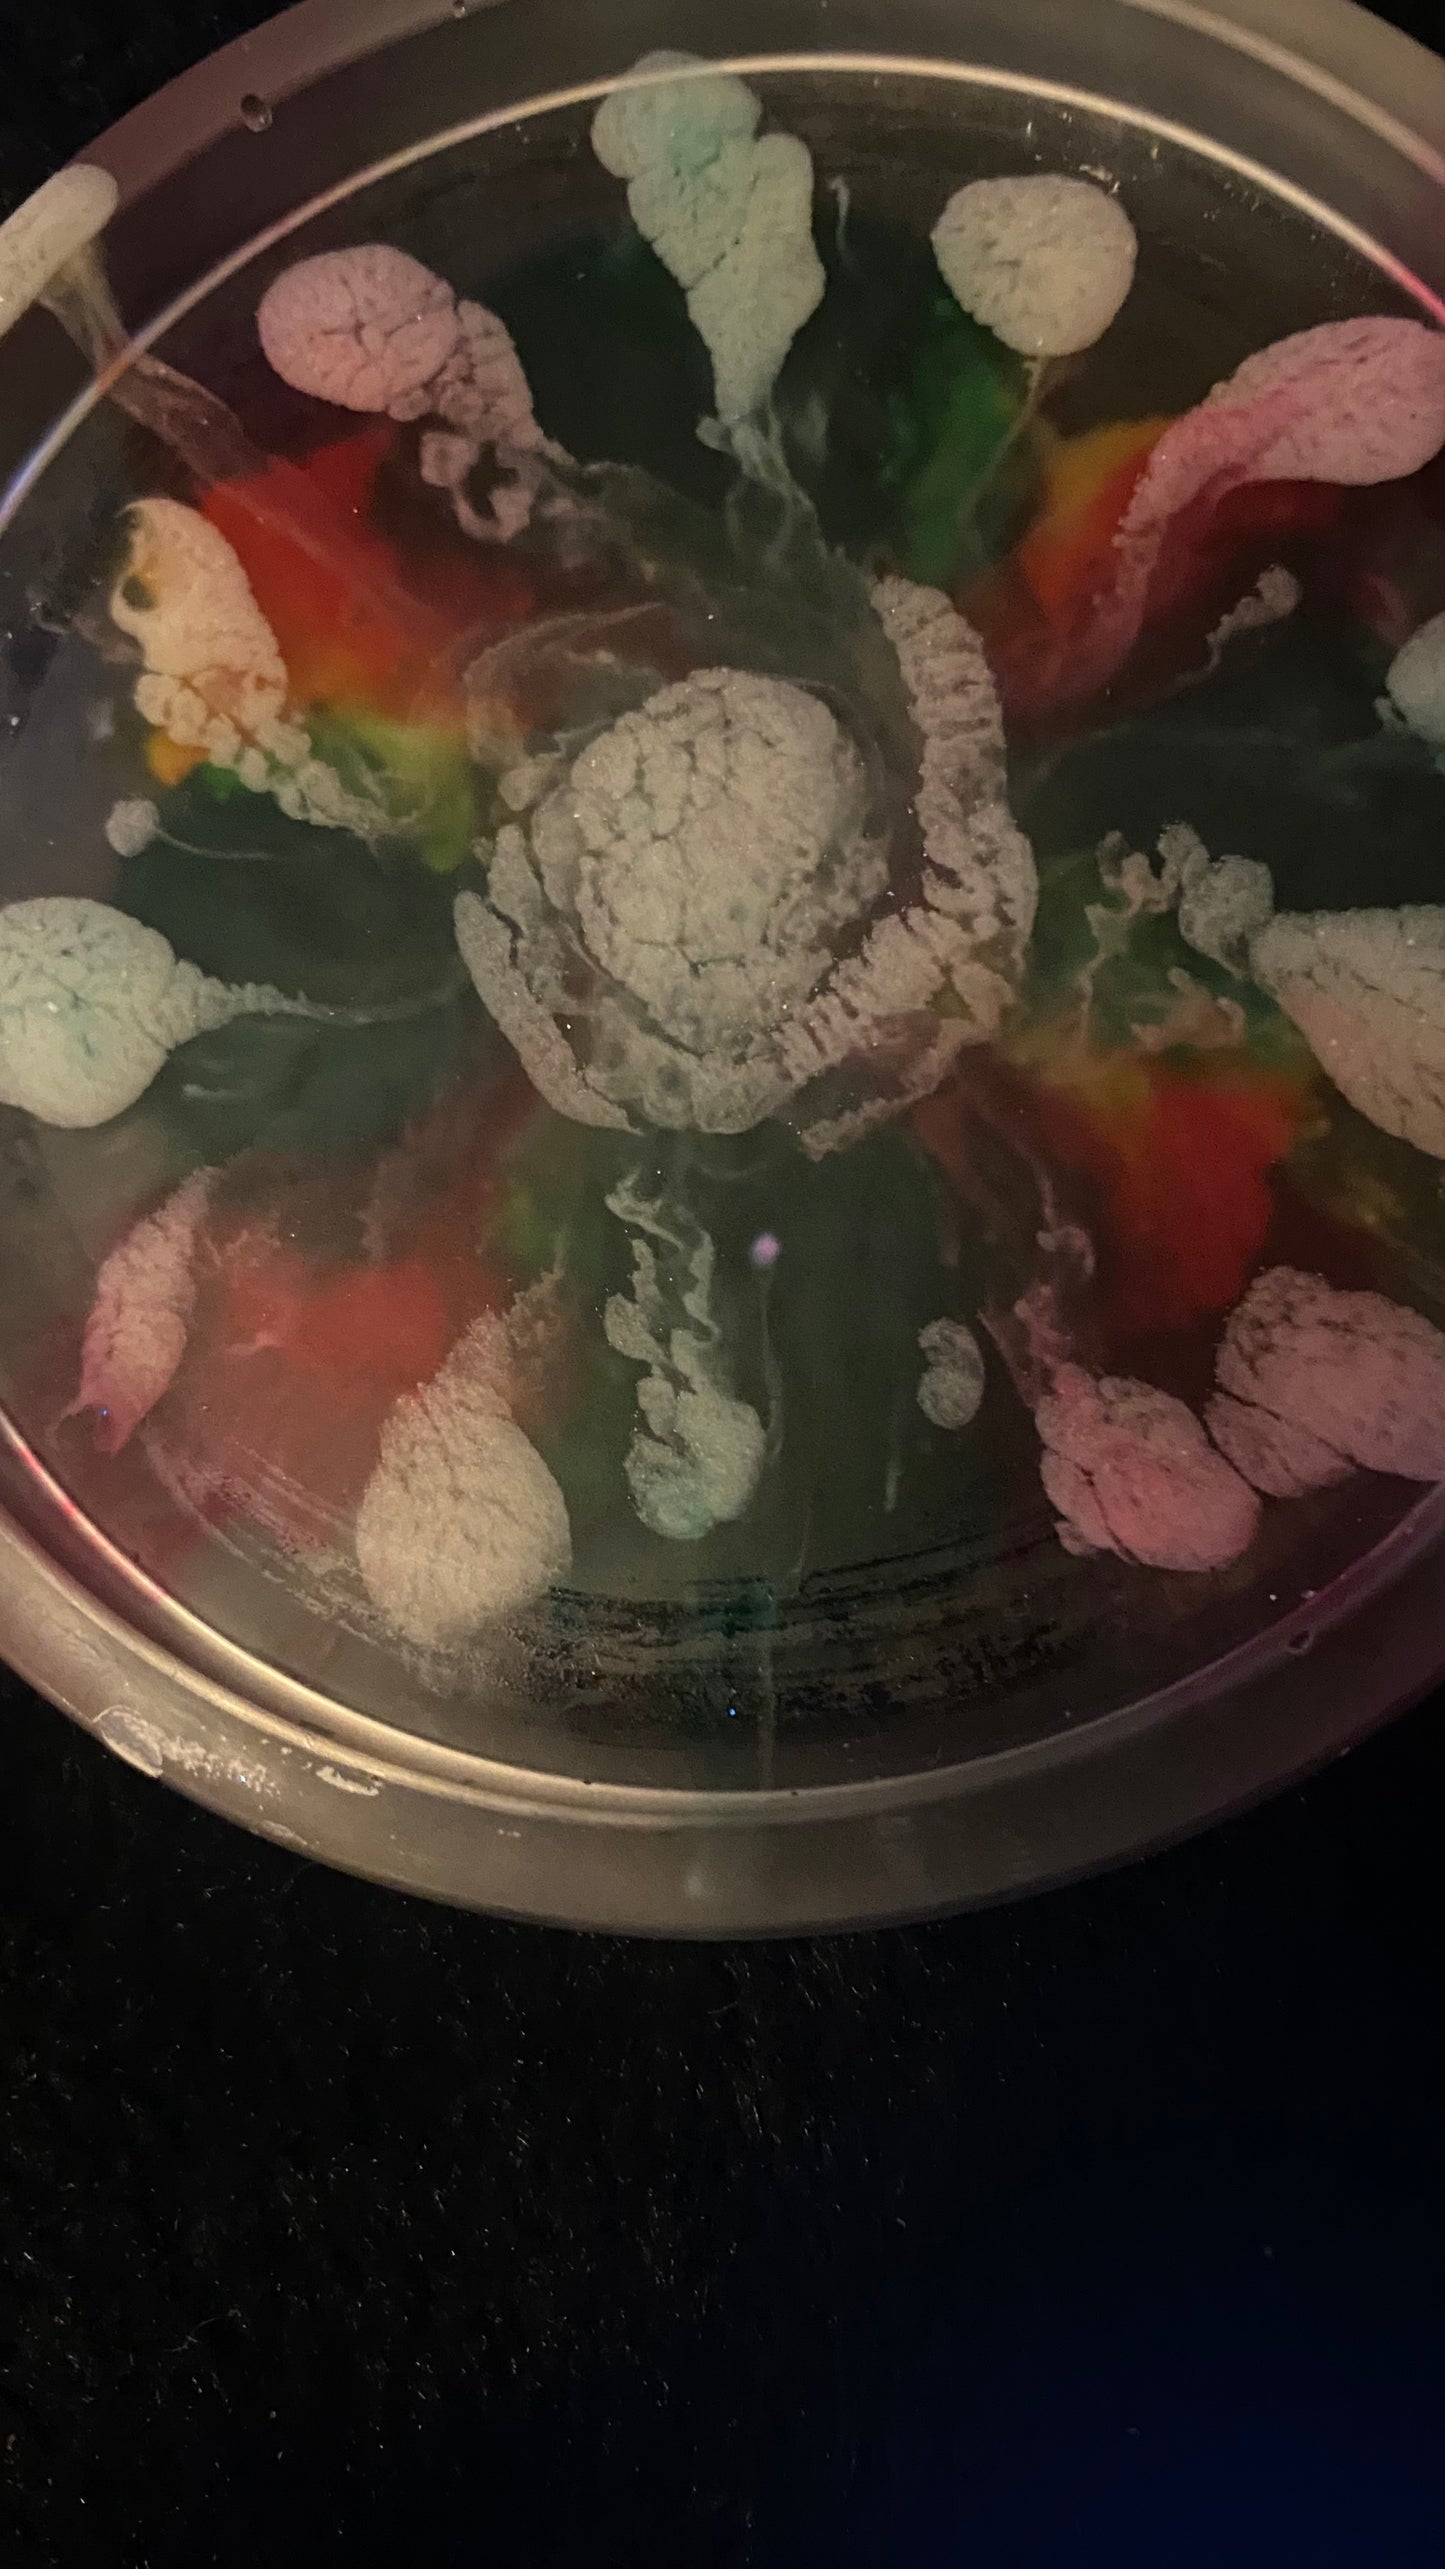

1
/
of
10
Hurricane Boutique
Multicolored Handmade Resin Coaster/Coin Tray
Multicolored Handmade Resin Coaster/Coin Tray
Regular price
$18.00 USD
Regular price
Sale price
$18.00 USD
Shipping calculated at checkout.
Quantity
Couldn't load pickup availability
Spice up your space with this groovy, handmade resin Art Deco coaster/coin tray.
Share